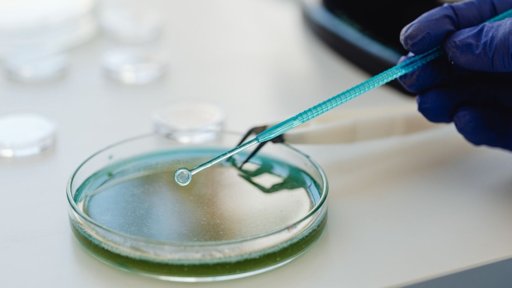
News Image

Jóvenes estudiantes mexicanos desarrollan proyectos científicos innovadores

Estudiantes de la Benemérita Universidad Autónoma de Puebla (BUAP) y de la Universidad Autónoma de Tamaulipas (UAT) han destacado por desarrollar proyectos de alto impacto. En la BUAP, las alumnas de Biotecnología, Luisa Renata López Lobato y Alexa Limón Bonilla, crearon NanoNatural, una alternativa natural a los pesticidas químicos para el control de hongos y bacterias en cultivos.
Su fungicida utiliza nanopartículas metálicas de cobre y titanio combinadas con residuos vegetales ricos en fitoquímicos, como brócoli y té verde, procesados mediante síntesis verde.
El proyecto está enfocado principalmente en combatir el hongo Mycosphaerella fijiensis, causante de la enfermedad Sigatoka que afecta a los plátanos, y la bacteria E. coli en alimentos empaquetados. Las pruebas de laboratorio demostraron que la formulación inhibe al 100 % el crecimiento del hongo. Gracias a esta propuesta, las estudiantes obtuvieron el primer lugar en dos concursos distintos: el de Proyectos de Emprendimiento Social Sostenible 2024 y el Quinto Encuentro Estatal de Jóvenes Investigadores 2024. Por otro lado, el talento de la UAT se proyecta a nivel global a través de Luis Fernando Aguinaga Rodríguez, alumno de la Escuela Preparatoria Mante. Aguinaga fungió como asesor del proyecto “Prototipo de un Parche Biométrico para la Regeneración Ósea Controlada”, presentado por Ian Rafael Morales Villanueva. La propuesta consiste en un parche de materiales biocompatibles que imita la estructura del tejido óseo para acelerar la recuperación de fracturas. Este trabajo, impulsado por el programa “Amor por la Ciencia” de la UAT, obtuvo la acreditación para presentarse en la Asia Pacific Conference for Young Scientists 2026 en Tailandia, tras su participación en la ExpoCiencias Nacional 2025.









